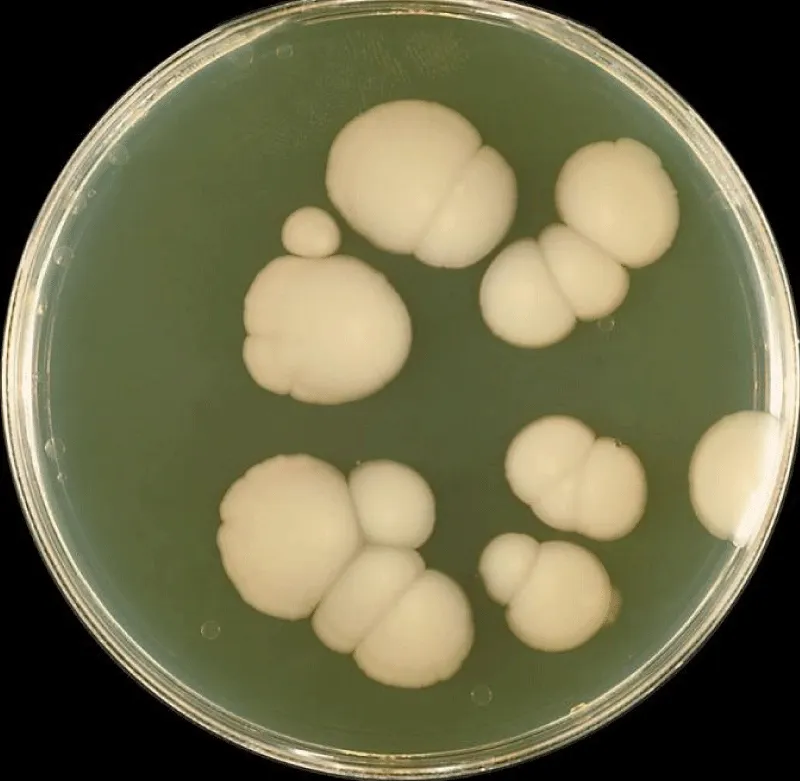

More Information
Submitted: January 29, 2026 | Accepted: February 03, 2026 | Published: February 04, 2026
Citation: Luisetto M, Ahmad KF, Rasool MG, Luca C, Yurevich LO. Chronic Chronic Prostatitis/Chronic Pelvic Pain Syndrome and Incomplete Response to Antibiotics: Fungal Infectious like Candida A. to be taken into Consideration in Some Subpopulations. Arch Case Rep. 2026; 10(2): 7-12. Available from:
https://dx.doi.org/10.29328/journal.acr.1001182
DOI: 10.29328/journal.acr.1001182
Copyright license: © 2026 Luisetto M, et al. This is an open access article distributed under the Creative Commons Attribution License, which permits unrestricted use, distribution, and reproduction in any medium, provided the original work is properly cited.
Keywords: Bacterial chronic prostatitis; Fungal; Candida; Seminal vesicle volume; Relapses; Antibacterial failure; Cultural test; Diabetes
Chronic Prostatitis/Chronic Pelvic Pain Syndrome and Incomplete Response to Antibiotics: Fungal Infectious like Candida A. to be taken into Consideration in Some Subpopulations
Luisetto Mauro1*, Khan Farhan Ahmad2, Mashori Ghulam Rasool3, Cabianca Luca4 and Latyshev Oleg Yurevich5
1IMA, Academy International, Applied Pharmacologist, Italy
2Professor, Department of Pharmacology, JNMC Aligarh Muslim University, India
3Professor, Department of Medical & Health Sciences for Women, Peoples University of Medical and Health Sciences for Women, Pakistan
4Medical laboratory Turin, Citta della Salute, Italy
5IMA, Academy International President, Italy
*Corresponding author: Luisetto Mauro, IMA Academy International, Applied Pharmacologist, Italy, Email: [email protected]
The aim of this work is to submit a specific case report of chronic prostatitis with incomplete response to antibiotics and the role played by Candida A, in the literature, it is reported that it is necessary to consider this pathogen in a specific subpopulation. The early consideration of this eventuality make possible to avoid dangerous delay in the right etiologic treatment. In this work, It is used a clinical pharmacy and pharmaceutical care approach. In this research is then submitted a specific case report to better explain the rationale.
Related to the classification of prostatitis, the chronic form can be divided into infective or not infective or abacteric.
In this work, the cases of chronic prostatitis not abacteric in a classic way, when the antibiotic therapy is not effective, with many relapses in the presence of one or more risk factors like diabetes, wide use of antibiotics, or retrograde urologic infections or other conditions.
Prostatitis is common and debilitating
“Prostatitis can be caused by chronic bacterial or fungal infections. Fungal prostatitis ie especially common in the elderly, hospitalised, catheterised, and immunosuppressed patients. Fungal prostatitis is commonly caused by the Candida species, especially Candida albicans and glabrata”.
“In the last decades, fungal urinary tract infections due to Candida yeasts have increased significantly.
The incidence of UTI associated with Candida albicans has recently been reported to be 6.8% of all microbial UTIs.
(MAGI) Male accessory gland infection includes infections (bacterial, viral, fungal, etc.) involving one or more of the following male genital organs or tracts: epididymis (epididymitis), vas deferens, seminal vesicles (seminal vesiculitis), prostate gland (prostatitis), Cowper’s glands, urethra (urethritis).
John F. Fisher, in 2011, wrote: “Candida species enter the upper urinary tract from the bloodstream (antegrade infection) or ascend the urinary tract UT from a focus of candidal colonisation at or near the urethra (retrograde infection).”
Morris B, et al. : “Mycotic infections are a common cause of balanitis. Candida species are the most prevalent, being found in approximately 1/3 of cases. While carriage of yeasts on the penis is common, symptomatic infection is seen more often in the uncircumcised males”.
Figure 1: Candida A culture.
Figure 2: From doi: 10.4239/wjd.v13.i10.809 Filamentous growth of Candida albicans in a vaginal specimen, with visible pseudohyphae and hyphae (magnification × 400).
Figure 3: From doi:10.4103/2156-7514.143734 Lesions of the Seminal Vesicles and their MRI Characteristics. Mahati N Reddy, Sadhna Verma.
With an observational point of view, various literature is reported, and a case report from the practical part.
After the analysis of this material, a global conclusion is submitted to the researcher.
All literature comes from biomedic scientific database.
The Figures reported (1-8) and the Table 1 help in the general meaning.
From literature According article 2023 Candida prostatitis: A rare entity.
Shabnam Singh, et al.: “Prostatitis may be acute and chronic bacterial infections (NIH Category I/II) or asymptomatic inflammatory prostatitis (NIH Category IV). Patients with a chronic prostatitis/chronic pelvic pain syndrome (CP/CPPS, NIH Category III) may present with a wide range of symptoms resulting from varied etiology seldom caused by fungal infections.
Occasional case reports have been published on prostatitis due to Candida sp. We report a case of an elderly diabetic patient who underwent perurethral prostatic resection for benign prostatic hyperplasia and returned with complaints of LUTS and perineal discomfort 1 month later. After repeat surgery, the TURP chips on histopathology showed features of prostate hyperplasia and prostatitis with numerous hyphae and yeast forms of Candida, admixed with acute and chronic inflammatory exudate. After the confirmation by special stains and positive urine culture, a final diagnosis of prostatic candidiasis was made [1].
Aykut Demirci, et al.: “Our patient was 51 years old and had lower urinary tract symptoms for 20 years.
Cytology revealed uniform bladder epithelial cells. Spore-bearing structures on the ground were seen in smear slides. They were considered Candida glabrata CG.
The patient began fluconazole 400 mg/day and doxazosin 4 mg/day. At the end of the 1 month, white particles in urine were significantly decreased, the patient’s IPSS score was 12, the pain score was 6, the urinary symptom score was 2, and the life quality index was 3 according to NIH-CPSI, and the symptoms were regressed in an obvious manner. In urine analysis, 48 erythrocytes and 9 leukocytes were detected. Urine culture was negative. In uroflowmetry, Qmax 16 ml/s, volume 370 cc, and average flow rate 12 ml/s, and the doxazosin was stopped. At the end of the 2 months, white particles in the urine disappeared completely. Fluconazole 400 mg/day was administered for a total of 8 weeks and then was discontinued. The patient was followedup for 6 months, and no recurrence was then observed.
Our case has shown that fungal agents should be considered especially in patients who do not respond to medical treatment [2].
Figure 4: From A Demirici, et al Microscopic findings of urine cytology.Emilio Mayayo, et al.
“Within the infectious prostatic processes, fungi can also be a specific cause of prostatitis. Fungal prostatitis FP often appears in patients with impaired immunity and can also be found in healthy patients. It can result from a disseminated infection, but it can also be localised. Fungal prostatitis FP is a nonspecific and harmless process. Diagnosis is commonly made by fine needle aspiration cytology or by biopsy” [3].
Ahmed Fouad Kotb, et al.: “Antifungal regimen should be considered for the majority of young adult men, presenting with chronic prostatitis/ chronic pelvic pain syndrome and incomplete response to the antibiotics” [4].
Zekaver Odabasi, et al.: “Candiduria is commonly seen in hospitalised patients, and most of the patients are asymptomatic, but it may be due to cystitis, pyelonephritis, prostatitis, epididymo-orchitis or disseminated candidiasis. Major risk factors are diabetes mellitus DM, indwelling urinary catheters, use of broad-spectrum antibiotics, urinary obstruction UO, and admission to intensive care units. Candida urinary tract infections can be caused by hematogenous spread following candidemia, or retrograde route via the urethra” [5].
Septimus, J.D. et al. Infectious Diseases in Clinical Practice 2006.
“With the increased use of antibiotics such as fluoroquinolones in these situations, as well as widespread use of other broad-spectrum antimicrobials, fungal infections FI in general have become more prevalent. Our case adds to this growing body of literature, suggesting that clinicians need to consider fungal infections FI in patients who fail standard therapy for prostatitis, either as a primary causative organism or as secondary agents induced by broad-spectrum antibiotic use.
After 1 month of antibiotics, his dysuria progressed to perineal discomfort and burning after urination. At that time, he was seen once again by urology. Urinalysis again showed 20-30 white blood cells and 20-30 red blood cells per high-power field, and rectal examination revealed a slightly boggy prostate with mild tenderness. Urine culture, prostate secretion cultures, and ejaculate cultures all grew Candida albicans CA at that time. Prostate ultrasound revealed no abscess.
The patient was diagnosed at that time with Candida prostatitis CP. He was started on fluconazole 400 mg daily for 6 weeks, with total resolution of symptoms after the first week of therapy. He is currently symptom-free over a year later, and follow-up urinalysis after treatment returned to normal” [6].
Wise G.J, et al. A. How to diagnose and treat fungal infections in chronic prostatitis. Curr Urol, 2006
“Diagnosis can be established by urine cultures or needle biopsy of the prostate PB. Prostate surgery for carcinoma or benign enlargement may detect latent fungal infection” [7].
https://www.candidaplan.com/candida-and-prostatitis/
Dr. McCombs: “Any male over 40 with a history of antibiotic use and swelling of the prostate, or urinary retention UR issues, should consider fungal candida as a possible cause” [8].
Tatfeng YM, et al.: “The presence of spermatozoa in the urine with yeast cells (Candida albicans CA) could be an indication of seminal sac infection” [9].
Vanessa Dias in 2020 reported: “Risk factors of candiduria (presence of Candida species in urine samples) and Candida urinary tract UT infections are well established, and include the extremes of age, female sex, diabetes mellitus, prolonged hospitalization, intensive care unit admission, immunosuppressive therapy, recent use of broad-spectrum antibiotics, previous surgery (urological and nonurological), radiation therapy, genitourinary tuberculosis, neutropenia, urinary tract UT instrumentation, transplantation, abnormalities of the urinary tract UT and catheterization, among others. Renal parenchymal infection should be treated in the same way as candidemia, using systemic antifungal agents. For the treatment of upper urinary tract infections due to the retrograde spread of Candida species, which occurs in patients with obstructive uropathy, diabetes mellitus DM and frequently concomitant bacteriuria, fluconazole is the antifungal agent of choice” [10].
Joana Rolo, et al.: “Semen has the ability to sustain C. albicans growth” [11].
A. E. Calogero, et al. in 2017: “Male accessory gland infection/inflammation is a generic acronym that indicates a set of inflammatory diseases of the male accessory sexual glands.
From a microbiological point of view, MAGIs are classified into microbial and inflammatory forms. There are many microorganisms potentially responsible for MAGI; the most common are Enterobacteriaceae (such as E. coli and Klebsiella sp.), Neisseria G., Chlamydia T, Ureaplasma urealyticum, Mycoplasma hominis, Candida albicans, and Trichomonas vag. MAGI is a consequence of canalicular spreading of agents via the urethra, prostate gland, seminal vesicles, deferent ducts, epididymis and testes.
Dohle, et al. [10] reported that in patients with a history of MAGI, 10% had abnormalities found on transrectal ultrasound of the prostate, such as oedema, dilatation of the seminal vesicles and ejaculatory ducts, intraprostatic calcifications and dilatation of the periprostatic venous plexus”.
Table 1: From doi:10.1038/aja.2012.49.
Figure 5: From doi:10.1038/aja.2012.49.
Mba, I.E. et al 2020: “Candida is the most implicated fungal pathogen in the clinical setting. Many factors play important roles in the pathogenesis of Candida spp. Multiple transcriptional circuits, morphological and phenotypic switching, biofilm formation, tissue damaging extracellular hydrolytic enzymes EHE, metabolic flexibility, genome plasticity, adaptation to environmental pH fluctuation, robust nutrient acquisition system, adherence and invasions (mediated by adhesins and invasins), heat shock proteins HSP, cytolytic proteins, escape from phagocytosis, evasion from host immune system HIS, synergistic coaggregation with resident microbiota, resistance to antifungal agents AA, and the ability to efficiently respond to multiple stresses are some of the major pathogenic determinants of Candida sp” [12].
N Jegadish, et al.: “The most common infectious etiology of balanoposthitis is Candida, followed by bacterial infections caused by Streptococcus sp. and Staphylococcus aureus, viral and parasitic infections. The factors which predispose to candidal balanoposthitis include diabetes mellitus, immunosuppression, uncircumcised penis, poor hygiene of the genitals, and tight prepuce” [13].
Meeta Singh, et al, 2024: “Fungal prostatic infections are relatively uncommon; The most common causes include blastomycesdermatitidis, Coccidioidesimmitis, and Cryptococcus neoformans. Aspergillus fumigatus, Histoplasma capsulatum, Candida albicans, and Candida glabrata are among the other rarer causes. Most fungal prostatitis occurs in urinary catheterisation and use of broad-spectrum antibiotics, leading to systemic hematogenous dissemination in immunocompromised patients and elderly hosts with comorbidities” [14].
Figure 6: From S. Dutta, et al. 2024; Mba, I.E., et al. 2020.
Figure 7: From Meeta Singh, et al. Hyphae and budding yeast forms of Candida, H&E stain, 400x, Inset: PAS stain, 400x.
Figure 8: From J Urol Res 12(1): 1161.
A case of an adult, 120 kg, age 60 years old, diabetes type II controlled with therapy, history of recurrent chronic prostatitis (more than 20 years, every 3 months, but also more frequent).
Normal flux if not congested, light ureteral restriction confirmed by retrograd uretroghraphy, abnormal urinary fluxumetry. Ecographic prostate: microcalcification present, and seminal vesicle volume increased.
Urologic inspection: normal volume.
Positive seminal liquid for Candida in recent times, Psa negative. Many times, sitting position during the day, reduced physical activity, and constipation. Great coffee intake daily, no smoking.
The previous culture was negative.
In the past positive culture for Ureaplasma.
Phimosis severe present
Worsening condition: alcohol intake greatly aggravates, spice use aggravates.
Starting episode: especially after a constipation episode, expecially or after prolonged sitting in a rigid sitting.
Haemorrhoids present, anal fissuration, history of low anal bleeding.
Ciproxin: good efficacy if prolonged 5-7-10 gg, Claritromycin good but relapses.
Sulfamidics – trimetroprim has good efficacy also in preventing, and Sporanox has good efficacy.
Tamsulosin is good to reduce bladder hyperactivity, Saccharomyces cerevisiae extract supp good to stop some episodes.
Fenolmicin P3 and Boisexil supp.,good efficacy if prolonged 3-5 days, Serenoa repens efficacy in reducing prostate pain and increase little the urinary flcus, Urtica dioica: efficacy.
Becloseton suppository alleviates, Saccharomyces Cerevisiae extract suppository alleviates (for competition with Candida A.).
Quality of life worsened significantly during the episode. Number of episodes: every month, but after Ciproxin prolonged (7-10 days) every 6 months.
Used also Sereona repens cps and urtica dioica with efficacy in quality of life, and to improve.
Urine flux
It was necessary to position a urinary catheter during a recent episode of urine retention.
By emergency urology ambulatory (30 days), the flux improved for 1 year, then a new restriction occurred.
Therapy with itraconazole: great reduction of symptoms after 2 cps, after 3 cps, great efficacy without using antibiotics. (1 cps at days = 100 mg) in last episode.
In a particular kind of subpopulation, like diabetic patients with problems of Candida growths, also in a retrograde way, it is also crucial to consider fungal pathology, especially if relapses occur with antibiotics and without neoplasm.
Obstructive uropathy, Prostatitis treated previous whit great use of antibiotics with failure, and phimosis.
Candida fungus can cause seminal vesicle inflammation (seminal vesiculitis), leading to enlargement, as semen supports its growth.
To be considered, the hypothesis of canalicular spreading of agents via the urethra, prostate gland, and seminal vesicles.
Through the transrectal ultrasound of the prostate, it is possible to see oedema, dilatation of the seminal vesicles and ejaculatory ducts, and intraprostatic calcifications.
Imaging (transrectal ultrasound) can show seminal vesicle enlargement.
Even if a positive seminal fluid culture for Candida A alone does not distinguish between colonisation, contamination, and true prostatic infection. No prostatic secretion culture, biopsy, histopathology, or repeated confirmatory cultures are presented related to the case report submiteed the clinical response to the itraconazole must be considered.
Crucial the microbiological culture, the cytology with special staining [2] or the result of biopsy [7] if needed by the patology.
In the case report submitted, the antifungal molecule chosen was decided by the general physicians observing the seminal fluid culture results and the clinical presentation with many relapses after antibiotic therapy in the presence of dilatation of the seminal vesicles.
Relates to the specific case report submitted in the practical part:
It is not accetable relapses in chronic prostatitis for a decade, as reported in this work [2] or in the case report submitted in the practical part:
It is proposed to the researcher to verify if it is necessary to modify the algorithm of diagnosis and treatment:
If there are many relapses after antibiotic therapy in the presence of one or two predisposing factors, it can be crucial to Exclude the fungal infections and evaluate the efficacy of an antimycotic.
Even if according iterature the first choice in this situation is fluconazole also itraconazol was able to produce clinical resolution. (better urinary flux, reduction of pain).
The right therapy of fungal origin makes it possible to reduce the antibiotics cicle (sometimes ineffective with a reduced possibility to produce new resistance) in some chronic prostatitis characterised by multiple relapses, even if treated with antibiotics.
The same antibiotic therapy can provide an environment that can increase the micotic infections.
Also, the cost of inappropriate therapy can be avoided.
Conflict of interest: no financial, commercial, or other affiliations were perceived as potential conflicts of interest by the academic community.
- Singh S, Singh M, Bains L, Sagar T. Candida prostatitis: a rare entity. Trop Doct. 2023;53(2):282–284. Available from: https://doi.org/10.1177/00494755221147962
- Demirci A, Bozlak N, Turkel S. Chronic prostatitis developing due to candida infection: a case diagnosed 20 years later and review of up-to-date literature. Urol Case Rep. 2018;20:88–89. Available from: https://doi.org/10.1016/j.eucr.2018.07.014
- Mayayo E, Fernández-Silva F. Fungal prostatitis: an update. Anal Quant Cytopathol Histpathol. 2014 Jun;36(3):167–176. Available from: https://pubmed.ncbi.nlm.nih.gov/25141493/
- Kotb AF, Ismail AM, Sharafeldeen M, Elsayed EY. Chronic prostatitis/chronic pelvic pain syndrome: the role of an antifungal regimen. Cent European J Urol. 2013;66(2):196–199. Available from: https://doi.org/10.5173/ceju.2013.02.art21
- Odabasi Z, Mert A. Candida urinary tract infections in adults. World J Urol. 2020;38(11):2699–2707. Available from: https://doi.org/10.1007/s00345-019-02991-5
- Septimus JD, Septimus EJ. Prostatitis due to Candida albicans. Infect Dis Clin Pract. 2006 Jul;14(4):239. Available from: https://doi.org/10.1097/01.idc.0000205843.05269.50
- Wise GJ, Shteynshlyuger A. How to diagnose and treat fungal infections in chronic prostatitis. Curr Urol Rep. 2006;7:320–328. Available from: https://doi.org/10.1007/s11934-996-0012-2
- Candida Plan. Candida and prostatitis [Internet]. Available from: https://www.candidaplan.com/candida-and-prostatitis/
- Tatfeng YM, Agba M, Nwobu GO, Agbonlahor DE. Candida albicans in urinary tract or in seminal sac. J Health Allied Sci. 2003;2(4). Available from: https://web-archive.southampton.ac.uk/cogprints.org/3501/1/2003-4-5.pdf
- Dias V. Candida species in the urinary tract: is it a fungal infection or not? Future Microbiol. 2020. Available from: https://doi.org/10.2217/fmb-2019-0262
- Rolo J, Caixeirinho P, Gomes-Ruivo P, Gaspar C, Fernandes I, Palmeira-de-Oliveira R, et al. Semen supports growth of Candida albicans: a putative risk factor for recurrence of vulvovaginal infections? J Obstet Gynaecol Res. 2020;46(9):1893–1899. Available from: https://doi.org/10.1111/jog.14367
- Mba IE, Nweze EI. Mechanism of Candida pathogenesis: revisiting the vital drivers. Eur J Clin Microbiol Infect Dis. 2020;39:1797–1819. Available from: https://doi.org/10.1007/s10096-020-03912-w
- Jegadish N, Fernandes SD, Narasimhan M, Ramachandran R. A descriptive study of the clinical and etiological profile of balanoposthitis. J Fam Med Prim Care. 2021 Jul;10(6):2265–2271. Available from: https://doi.org/10.4103/jfmpc.jfmpc_2467_20
- Singh M, Singh S, Khurana N, Pandey N, Bhatt VR, Thomas S, et al. Histopathological evaluation of prostate lesions: a comprehensive approach. IntechOpen. 2024 Sep 16. Available from: https://doi.org/10.5772/intechopen.1006651